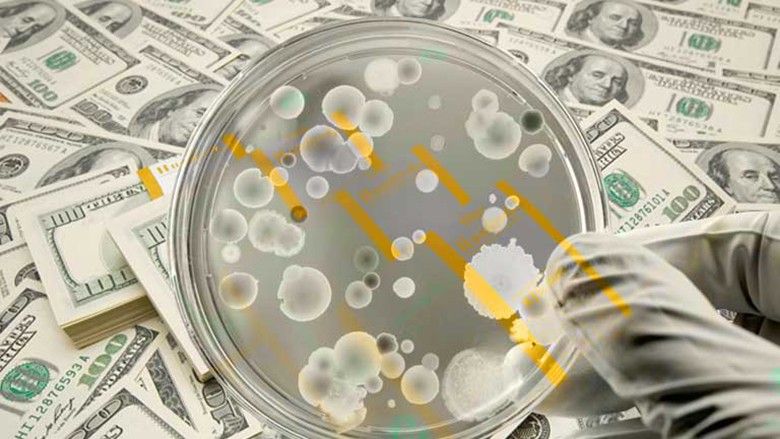
2017/03/DirtyMoney.jpg

A e dini se sa vërtet paratë janë të pista? Në kuptimin e drejtpërdrejtë të fjalës!
Paratë vërtet janë të pista – kjo nuk është ndonjë risi. Mirëpo, a e keni ditur se cilat baktere jetojnë në bankënota?
Shkencëtarët e Universitetit të Nju-Jorkut ia kanë nënshtruar bankënotat analizës ADN prej një dollari dhe kanë zbuluar që në to ka 3.000 lloje bakteresh, transmeton Telegrafi.
Ndër llojet më të shpeshta të baktereve në bankënota janë ato të cilat shkaktojnë akne dhe bakteret të cilat shkaktojnë probleme në zorrë, inflamacion të mushkërive madje edhe dështim të veshkave.
Në një numër të madh të bankënotave është gjetur edhe MRSA-ja potencialisht vdekjeprurëse.
Mirëpo, shkencëtarët më së shumti i ka befasuar kur kanë zbuluar që mikrobet pikërisht rriten në bankënota dhe shumëzohen në to.
Këto janë bakteret më të shpeshta në bankënota:
1. Streptokoku
Streptokoku shkakton inflamacion të fytit, infeksion të lëkurës, infeksion të traktit të urinës madje edhe inflamacion të mushkërive.
Edhe pse disa tipe të saj janë të padëmshme, disa të tjera janë vdekjeprurëse. E.coli krijon anemi dhe probleme me veshkën, të cilat mund t’iu çojnë drejt vdekjes. Shumë njerëz që preken nga ky mikrob vuajnë nga dhimbjet e stomakut, vjellin dhe kanë diarre.
3. Salmonela
Salmonella Enterica është një nga shkaktarët kryesor të helmimit të ushqimit. Ky mikrob trasmetohet dhe përhapet edhe përmes parave.
4. Stafilokoku i artë
Stafilokoku i artë është bakter shumë rezistues ndaj antibiotikëve Shkakton infeksion të lëkurës, inflamacion të bajameve, sinuseve dhe syve, mirëpo edhe sëmundje të vështira si p.sh. hematoksi, inflamacioni i mushkërive, sindroma e shokut toksik dhe meningjitin.
5. MRSA
MRSA-ja është stafilokok i artë rezistues ndaj antibiotikëve me spektër të gjerë. Mund të shkaktojë vdekjen e indeve.
Prandaj, gjithmonë pasi që të keni prekur paratë, nëse keni mundësi, lani duart. Nëse jo, kini kujdes që me to të mos e prekni fytyrën dhe mos i vini në gojë. /Telegrafi/